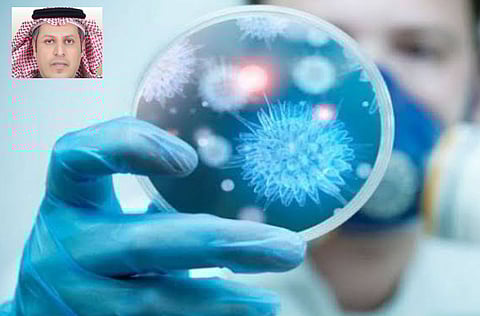
الذايدي لـ"سبق": السعودية آمنة من "كورونا".. وليس كل مصاب بـ"الفيروس" سيموت

- "كورونا" فيروس مثل الإنفلونزا ينشط في الشتاء ويتلاشى في الصيف.. والإثارة الإعلامية "أرعبت" الناس.
- الدولة تقوم بجهود جبارة على المنافذ البرية والجوية والبحرية والفِرَق الطبية تعمل بكل احترافية لمنع كورونا.
- العطاس والرذاذ المتطاير من المصاب يسبب العدوى.. والأعراض زكام وحمى وضيق التنفس وسعال.
- مثل هذه الأوبئة فرصةٌ لنا لتغيير سلوكنا في السلام و"التقبيل" والاكتفاء بالمصافحة في المناسبات الاجتماعية.
- "الفيروس" سلالة جديدة لم يسبق التعرف عليه ويتراوح بين نزلات البرد إلى الالتهابات الرئوية الحادة.
- هذا السبب الحقيقي لإصابة الخليجيين.. وإيران موبوءة تفتقد لأبسط معايير الوقاية من الأمراض المعدية.
- "كورونا" لا يطير في الهواء فلا داعي للبس الكمام في الأماكن العامة.. وفترة الحضانة أسبوعين.
- الفيروس غير "مصنّع" في المختبرات.. وكثرة الصينيين وسلوكهم الغريب في الأكل جعلها مصدر الأوبئة.
حوار- شقران الرشيدي: أكد طبيب الأسرة والمجتمع الدكتور عواد الذايدي، أن السعودية آمنة بإذن الله من انتشار وباء كورونا، وأن الجهود الجبارة التي تبذلها الدولة في هذا الصدد، ممثلة في مركز القيادة والتحكم حيث تعمل على جميع المنافذ البرية والجوية والبحرية بفِرَق طبية تعمل بكل احترافية، وخطوات استباقية لمنع دخول حالات مصابة؛ مشيرًا إلى أن منظمة الصحة العالمية أثنت على هذه الجهود.
وقال "الذايدي" في حواره مع "سبق": إن "كورونا" يصيب الجنسين، وجميع الأعمار، والأغلب هم من الأعمار المتوسطة، والسبب منطقي لأنهم هم الأكثر عددًا في التركيبة السكانية، وكبار السن هم الأكثر خطرًا في مراحل تطور المرض والإصابة بالالتهاب الرئوية، كما أن الدراسات أثبتت أن الأطفال أقل عرضة للإصابة.
وأكد أن نسبة الشفاء من الفيروس تصل إلى ٩٨٪؛ ولكنّ الإعلام الدولي دائمًا يبحث عن الإثارة، وهذا أمر طبيعي للفت الانتباه والتسويق لمؤسساتهم الإعلامية.
وأشار "الذايدي" إلى أن سبب انتشار الفيروس في الصين، أنها تمثل حوالى ربع سكان العالم تقريبًا، وسلوكهم الغريب في الأكل؛ مؤكدًا أن إيران أصبحت منطقة موبوءة وتفتقد لأبسط معايير الوقاية الأساسية للتعامل مع الأمراض المعدية.
وتناول الحوار عددًا من المحاور الصحية المهمة فإلى التفاصيل.
** يكثر الحديث عن فيروس "كورونا" الجديد فمن أين أتى؟
فيروس كورونا المستجد، هو سلالة جديدة من الفيروسات الذي لم يسبق التعرف عليه بين البشر، وهو أحد مجموعات فيروسات الكورونا التي تتراوح الإصابة بها في البشر بين نزلات البرد البسيطة إلى الالتهابات الرئوية الحادة، وتتمثل أبرز أعراض الإصابة بالمرض في التهابات الجهاز التنفسي البسيطة مثل الزكام العادي مع الحمى، وضيق التنفس، والسعال، وتختلف حسب حدة الإصابة وقوة المرض وحصول الالتهابات الرئوية الشديدة؛ ولكن بنسبة أقل، ومدة الحضانة الخاصة بالفيروس الجديد غير معروفة تمامًا ولكن فترة الحضانة للأنماط المعروفة لفيروس (كورونا) تتراوح بين أسبوع إلى أسبوعين، وهي في الغالب لا تختلف عنها.
** كيف ترون الجهود التي تقوم بها المملكة في مكافحة فيروس كورونا من الدخول لأراضيها؟
لا شك أنها جهود جبارة ممثلة في مركز القيادة والتحكم حيث تعمل على جميع المنافذ البرية والجوية والبحرية، بفِرَق طبية تعمل بكل احترافية وخطوات استباقية لمنع دخول حالات مصابة؛ خاصة أن المملكة تمتاز بخصوصية وجود الأماكن المقدسة، وقد أثنت منظمة الصحة العالمية على هذه الجهود من قِبَل الفريق المختص، ومما شاهدناه من عمل نكاد نجزم -بإذن الله- أن المملكة آمنة من انتشار الوباء، وأُطَمْئِن الجميع إلى أنه لا خوف من الفيروس.
** هل التواجد في الدول المنتشر فيها هذا الفيروس أو بين المصابين به، كفيل بنقل العدوي؟ أم هناك طُرُق للإصابة بهذا الفيروس؟
الفيروس ينتقل عن طريق العطاس المباشر من شخص مصاب أو وجود الفيروس على الأسطح ولمسه باليد مباشرة، ومن ثم لمس الأنف أو الفم؛ لذلك ننصح دائمًا بغسل اليدين، وتجنّب لمس الأنف والفم، كما أشدد على تجنب السفر للدول التي انتشر فيها المرض، وإذا اضطر المرء للسفر يكون حريصًا على عدم الاختلاط والقرب من الأشخاص قدر المستطاع.
** هناك معلومة تتردد بأن كل مَن يُصاب بالفيروس سيموت؛ فإلى أي مدى صحة هذه المعلومة؟
معلومة غير صحيحة طبعًا؛ بل إن نسبة الشفاء من الفيروس تصل إلى ٩٨٪ وهي نسبه عالية جدًّا.
** ما سبب الإصابة الكبيرة بين الخليجيين القادمين من إيران؟ هل الأمر يتعلق بمناعة ضعيفة أم إهمال صحي؟
هذا إن دل فهو يدل على أن إيران أصبحت منطقة موبوءة وتفتقد لأبسط معايير الوقاية الأساسية للتعامل مع الأمراض المعدية، وهو ليس أمرًا غريبًا على بلد مثل إيران لا تهتم بالمواطن كما تهتم بسياستها العبثية مع دول الجوار، وإصابة عدد من المواطنين الخليجيين يعود إلى أنهم زاروا أماكن دينية في إيران مكتظة بالبشر وأصيبوا بالعدوى.
** كيف يمكن للإنسان العادي الوقاية من الإصابة بفيروس كورونا؟
فيروس كورونا مثل أغلب الفيروسات يكون ضعيفًا خارج الجسم، ولا يعيش أكثر من ساعات؛ ولذلك أفضل الطرق للوقاية منه هو الابتعاد عن أي شخص مصاب بأعراض الإنفلونزا؛ سواء ثبت تشخيصه بالكورونا أو لم يثبت؛ لأن الأعراض متشابهة، والأفضل الابتعاد، والفيروس ينتقل عن طريق العطاس، والرذاذ المتطاير من الشخص المصاب.. ولعلها فرصة لتغيير سلوك المجتمع مثل التقبيل في المناسبات الاجتماعية، ونكتفي بالمصافحة أو السلام من بعيد خاصة في أوقات انتشار الأوبئة؛ حتى تصبح عاده مجتمعية.. والمجتمع السعودي بعد رؤية المملكة ٢٠٣٠ أصبح أكثر وعيًا وقادرًا على التغيير للأفضل. والفيروس بطبيعته لا يطير في الهواء كما يعتقد البعض؛ فلا داعي للبس الكمام في الشارع والأماكن العامة إن لم يكن هناك ازدحام وتقارب مباشر مع أشخاص مصابين أو متوقع إصابتهم.
** هل حرارة الجو في الصيف تُقلل من انتشار الفيروس والإصابة به؟
الفيروس يحمل مواصفات الإنفلونزا بشكل كبير، والتي في الغالب تنشط في فصل الشتاء، وتبدأ تضعف وتتلاشى مع بداية دخول فصل الصيف، وهذا ما سيحدث -بإذن الله- مع فيروس كورونا.
** هل يستحق فيروس كورونا كل هذا الذعر الكبير الذي سبّبه؟ أم أنها إثارة إعلامية مبالغ فيها؟
بلا شك لا يستحق كل هذا الذعر، والإثارة الإعلامية مبالغ فيها، والسبب يعود إلى أن نسبة الشفاء من الفيروس مشابهة للأنفلونزا الموسمية وهي عالية جدًّا، ولكن الإعلام دائمًا ما يبحث عن الإثارة وهذا أمر طبيعي للفت الانتباه والتسويق لمؤسساتهم الإعلامية، كما أرفع القبعة لصحيفة "سبق" الإلكترونية على الشفافية في الطرح دون تهويل أو تضخيم للحدث.
** كيف يمكن توعية المجتمع لتجنب الإصابة بكورونا؟
كما ذكرنا سابقًا، عدم الاختلاط بالأشخاص المصابين أو المشكوك في إصابتهم، وفي حال الضرورة حماية الأنف والفم، ونظافة اليدين بشكل مستمر.
** مَن هم أكثر الأشخاص المعرّضين للإصابة؟ ولماذا؟
الفيروس يصيب الجنسين، وجميع الأعمار، والأغلب هم من الأعمار المتوسطة والسبب منطقي، ويعود لأنهم هم الأكثر عددًا في التركيبة السكانية، وكبار السن هم الأكثر خطرًا في تطور المرض والإصابة بالالتهابات الرئوية، كما أن الدراسات أثبتت أن الأطفال هم أقل عرضة للإصابة، وهذا قد يعني أن الأطفال يصابون بنموذج أخف من المرض؛ بحيث لا تظهر عليهم أي أعراض؛ مما يؤدي في نهاية المطاف إلى تجنّب أهاليهم والتوجه بهم إلى الأطباء أو المستشفيات؛ وبالتالي إلى عدم تسجيل حالات إصاباتهم.
** متى تتوقع انتهاء هذا الفيروس؟
بإذن الله مع نهاية فصل الشتاء، وبداية دخول فصل الصيف؛ سيضعف الفيروس ويتلاشى بشكل كبير.
** هل هو فيروس مصنّع في المختبرات كما يتردد؟ أم فيروس بكتيري ناتج عن عدم الاهتمام بنظافة الأكل؟
فيروس كورونا غير مصنّع في المختبرات؛ بل هو مثل أغلب الفيروسات يغيّر في تركيبته الجينية من فترة لأخرى، ويظهر بشكل جديد.. وللعلم الفيروس لا يختفي بل يخمد وينشط من جديد في فصل الشتاء، وتختلف حدته وشراسته حسب تركيبته الجديدة.
** لماذا تنتشر هذه الفيروسات من الصين تحديدًا؟
الصين تُعتبر ربع سكان العالم؛ فلا غرابة أن تبدأ منها الأمراض والأوبئة والفيروسات وغيرها، بالإضافة إلى سلوكهم الغريب في الأكل؛ وهو ما يُعَد أقوى النظريات في مصدر الفيروس حيث بداية انتشار المرض في مدينة "ووهان" الصينية في سوق الأسماك تحديدًا، والذي يباع فيه أنواع الحيوانات والمخلوقات البحرية، ولا تزال هذه النظريات غير مثبتة بشكل نهائي؛ ولكن يجب الاحتراز، وطهي اللحوم بشكل جيد.
** هل يوجد علاج فعال لفيروس كورونا؟
فيروس كورونا مثل أغلب الفيروسات، لا يوجد له علاج فعال يقضي عليه، ولكن من لطف الله أنه يضعُف وينتفي من تلقاء نفسه؛ وهو ما نشاهده. وحتى الآن لا يوجد لقاح محدد له على مستوى العالم وما زالت الأبحاث مستمرة في هذا المجال.